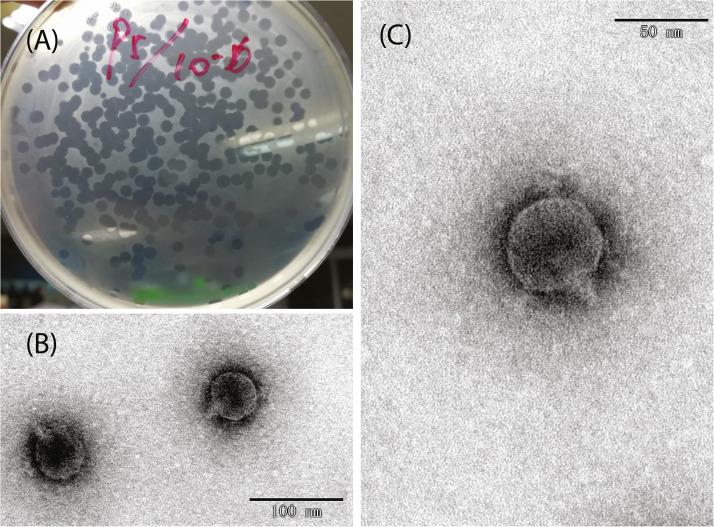
https://cdn.ncbi.nlm.nih.gov/pmc/blobs/a202/10194157/294abb120dba/gr1.jpg

揭示模型大肠杆菌 C600 菌株对裂解 T4 样和 T7 样噬菌体的易感性和抗性的决定因素。
Uncovering the determinants of model Escherichia coli strain C600 susceptibility and resistance to lytic T4-like and T7-like phage.
机构信息
College of Veterinary Medicine, Yangzhou University, Yangzhou, Jiangsu 225009, China; Jiangsu Co-Innovation Center for Prevention and Control of Important Animal Infectious Diseases and Zoonoses, Yangzhou 225009, China; Priority Academic Program Development of Jiangsu Higher Education Institutions (PAPD), Yangzhou 225009, China.
College of Veterinary Medicine, Yangzhou University, Yangzhou, Jiangsu 225009, China; Jiangsu Co-Innovation Center for Prevention and Control of Important Animal Infectious Diseases and Zoonoses, Yangzhou 225009, China; Priority Academic Program Development of Jiangsu Higher Education Institutions (PAPD), Yangzhou 225009, China.
出版信息
Virus Res. 2023 Feb;325:199048. doi: 10.1016/j.virusres.2023.199048. Epub 2023 Jan 18.
As antimicrobial resistance (AMR) continues to increase, the therapeutic use of phages has re-emerged as an attractive alternative. However, knowledge of phage resistance development and bacterium-phage interaction complexity are still not fully interpreted. In this study, two lytic T4-like and T7-like phage infecting model Escherichia coli strain C600 are selected, and host genetic determinants involved in phage susceptibility and resistance are also identified using TraDIS strategy. Isolation and identification of the lytic T7-like show that though it belongs to the phage T7 family, genes encoding replication and transcription protein exhibit high differences. The TraDIS results identify a huge number of previously unidentified genes involved in phage infection, and a subset (six in susceptibility and nine in resistance) are shared under pressure of the two kinds of lytic phage. Susceptible gene wbbL has the highest value and implies the important role in phage susceptibility. Importantly, two susceptible genes QseE (QseE/QseF) and RstB (RstB/RstA), encoding the similar two-component system sensor histidine kinase (HKs), also identified. Conversely and strangely, outer membrane protein gene ompW, unlike the gene ompC encoding receptor protein of T4 phage, was shown to provide phage resistance. Overall, this study exploited a genome-wide fitness assay to uncover susceptibility and resistant genes, even the shared genes, important for the E. coli strain of both most popular high lytic T4-like and T7-like phages. This knowledge of the genetic determinants can be further used to analysis the behind function signatures to screen the potential agents to aid phage killing of MDR pathogens, which will greatly be valuable in improving the phage therapy outcome in fighting with microbial resistance.
随着抗菌药物耐药性(AMR)的不断增加,噬菌体治疗作为一种有吸引力的替代方法重新出现。然而,噬菌体耐药性发展和细菌-噬菌体相互作用的复杂性的知识仍未得到充分解释。在这项研究中,选择了两种裂解 T4 样和 T7 样噬菌体感染模型大肠杆菌菌株 C600,并使用 TraDIS 策略确定了参与噬菌体易感性和抗性的宿主遗传决定因素。裂解 T7 样噬菌体的分离和鉴定表明,尽管它属于噬菌体 T7 家族,但编码复制和转录蛋白的基因表现出高度的差异。TraDIS 结果鉴定了大量以前未被识别的参与噬菌体感染的基因,其中一部分(敏感性的 6 个和抗性的 9 个)在两种裂解噬菌体的压力下是共有的。易感基因 wbbL 的值最高,表明其在噬菌体易感性中起着重要作用。重要的是,还鉴定了两个易感基因 QseE(QseE/QseF)和 RstB(RstB/RstA),它们编码相似的双组分系统传感器组氨酸激酶(HKs)。相反,奇怪的是,外膜蛋白基因 ompW 与编码 T4 噬菌体受体蛋白的基因 ompC 不同,它显示出提供噬菌体抗性的能力。总的来说,这项研究利用全基因组适应性测定法揭示了对两种最流行的高裂解 T4 样和 T7 样噬菌体的大肠杆菌菌株的敏感性和抗性基因,甚至是共享基因,这对噬菌体治疗抵抗微生物耐药性具有重要意义。对这些遗传决定因素的了解可以进一步用于分析潜在的功能特征,以筛选潜在的药物来帮助噬菌体杀死多药耐药病原体,这在提高噬菌体治疗对抗微生物耐药性的效果方面将具有巨大的价值。